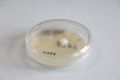
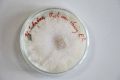
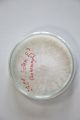

supermarket piracy programm
Oyster mushroom cloning series stage 1 (obtained from Globus supermarket; polish origin)
Brown Button mushroom cloning series stage 2 and stage 3 ( obtained from Rewe supermarket; german origin)
Artistic Abstract
To address the growing issue of patented living organisms, I pirate the genome of store-bought mushroom-products and distribute the organism in the form of viable mycelium, for everyone to grow and distribute the organism, in a respectful way.
Scientific Abstract
Specimen of mushrooms obtained from supermarkets are cloned and the developing strain is purified, than stored in a cold-storage strain-bank. Via reverse-engineering the strain from a commercial product is extracted and cultured. The strains will be given away, and kept available.
Method
For every attempt of cloning at least seven petri-dishes filled with PDA- medium are inoculated. The scalpel is sterilized in a hot flame till it glows red. It then is cooled in the receiving petri dish. The mushroom is ripped apart in the middle. Tissue then is taken from just above the gills, inside the stem or just under the cap. It is inserted in the hole that the hot scalpel made. The dishes are labeled and incubated in the incubator (23°-25° C). The mycelium that emerges is purified by running it through subsequent petri dishes till there is no visible evidence of contaminants. Then it is stored in test-tubes filled with PDA- medium at temperatures below 5°C. Two tubes per strain, enveloped in a zip-loc-bag. ( liquid suspended-animation technique will be introduced.)
References
Paul Stamets and J.S. Chilton: The Mushroom Cultivator; Sterile Technique and Agar Culture: Starting a Culture From Live Tissue (p. 29) 1983 Agarikon Press Olympia Washington ISBN: 978-0-9610798-0-2 Paul Stamets: Growing Gourmet and Medicinal Mushrooms (Third Edition); Culturing Mushroom Mycelium on Agar Media: Starting a Mushroom Strain by Cloning (p. 88); 2000 Ten Speed Press ( Random House New York) ISBN: 978-1-58008-175-7
The digital lab-book ( this is the unedited version of the lab-book, that will be the most up-to-date document)